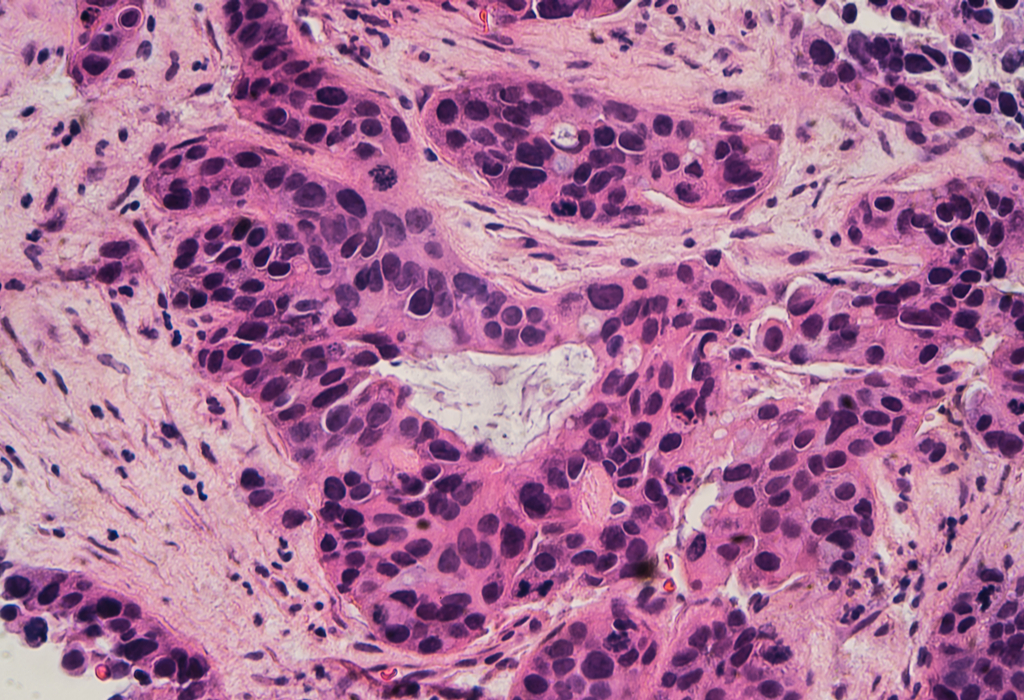

Breast Cancer Advances, Slower Hurricanes, and Peacock Problems
7:20 minutes
Last week, researchers reported in the New England Journal of Medicine that about 70 percent of women diagnosed with the most common type of breast cancer may be able to avoid chemotherapy and maintain the same chances of survival as women who undergo chemo—opening the door for an easier treatment regimen. Plus, a highly experimental immunotherapy treatment called adoptive cell therapy appears to successfully have eliminated cancer for one woman, though it isn’t successful for all
Tanya Basu, science editor at The Daily Beast, joins Ira to talk about the trials, and other stories from the week in science, including work on hurricane speed, the volcanic eruption in Guatemala, and the strange story of a town in British Columbia with a peacock problem.
Tanya Basu is science editor at The Daily Beast in New York, New York.
IRA FLATOW: This is Science Friday. I’m Ira Flatow. A bit later in the hour, we’ll check in on the hunt for the elusive dark matter and why it’s so hard to find. Well, it is dark, but there’s much more to this story. First, last week researchers reported in The New England Journal of Medicine that many women with breast cancer may be able to avoid chemotherapy and maintain the same chances of survival as women who do get chemo. And that may mean an easier treatment regimen for about 70% of women diagnosed with the most common type of breast cancer.
Tanya Basu, Science Editor at The Daily Beast, is here to talk about that research and other selected short subjects in science this week. She’s in our New York studios. Welcome to your first time on Science Friday.
TANYA BASU: It is my first time. Thank you for having me.
IRA FLATOW: You’re very well. Let’s talk more about this breast cancer news. Many people may not need chemotherapy.
TANYA BASU: Yeah. So this study goes back from 2006 and there were thousands of women– 10,000 women, I think– that were studied. They’re middle-stage cancer. They all get surgery. And then they get put in two different paths. They either get endocrine therapy or they get chemotherapy. It turns out the women who went through endocrine therapy, basically the same results as those who went through chemotherapy. And now researchers are saying, why are we putting them through all this radiation, if it’s not necessary?
IRA FLATOW: So that sounds like it’s great news, because chemotherapy, as you say, can be very difficult.
TANYA BASU: Very toxic.
IRA FLATOW: And be toxic.
TANYA BASU: And of course, endocrine therapy has some drawbacks as well– hormonal imbalances and stuff– but it’s still not as bad and as just physically hard.
IRA FLATOW: So this is for the great majority of women with breast cancer?
TANYA BASU: Yeah, with middle-stage breast cancer.
IRA FLATOW: Wow. What news– that’s great news. Thanks. And so let’s go into some other news. There’s been a big potential immunotherapy advance.
TANYA BASU: Yeah. So a 42-year-old woman from Florida went through immunotherapy, which is using your own body’s immune system. This is even better than endocrine therapy.
IRA FLATOW: Better than chemotherapy, which kills stuff.
TANYA BASU: Exactly. And so she’s using her own immune system to basically fight cancer. She was given three years to live. It’s been two years and she’s cancer-free. So very promising. We don’t really know yet if this is going to be something we can keep advancing, but definitely something to look into.
IRA FLATOW: Because only a minor number of people who get immunotherapy actually respond positively. Right?
TANYA BASU: Yeah, so it’s in its early stages.
IRA FLATOW: Yeah, but the people who do respond, really respond well.
TANYA BASU: They respond beautifully. I mean, look at this, cured of cancer.
IRA FLATOW: Wow! That’s really good stuff to follow. Well, let’s go on to fast-forward to backwards. Let’s go– last week we talked about the seasonal hurricane forecast for the months ahead. But there is a new study saying that the future outlook for storms could be stormy.
TANYA BASU: Oh, yeah, very stormy. So these researchers took 22 hurricanes and then simulated them in 2100– the year 2100– when climate change is supposed to make the world 9 degrees warmer. And they found it’s going to be pretty bad. So winds are going to be 6% faster, rainfall is going to be– there’s going to be 24% more rain, and 9% slower movement of hurricanes. That sounds good, but it’s actually bad. When a hurricane moves slowly, it means that there is just more potential for damage.
IRA FLATOW: Wow! So are the winds in the hurricane going to change how they work or they move?
TANYA BASU: They’re going to be probably much more violent just by nature of how slowly the hurricanes are moving. And so that’s some really interesting, yet scary stuff coming ahead of us.
IRA FLATOW: Yeah, because we’ve had one heck of a winter. The Nor’easters in the wintertime. Now we’re going to see about the hurricanes.
TANYA BASU: And we’re only one week into hurricane season.
IRA FLATOW: Wow!
[LAUGHTER]
So is it possible that– and I remember in the summertime– I remember seeing because of climate change, I remember I saw a news report that Australia had to change the color of its map for heat, because they didn’t have a number high enough to go past about 120 Fahrenheit.
TANYA BASU: Yeah, so there’s actually some people who are proposing six categories of hurricanes.
IRA FLATOW: You could have a category six hurricane?
TANYA BASU: We’re at five right now. But there’s some controversy and backlash at this, because category five is already dangerous and a lot of people don’t really respond. They’re like, no, we’re going to stay here, we’re going to keep our house and everything. If there’s a six that comes into play, are people going to be like, oh, if it’s a five, it’s not as bad as a six, I’m going to just stay? Which is faulty thinking, but it’s human behavior and it could be dangerous.
IRA FLATOW: All right, well, speaking of dangerous, let’s talk about the volcanic eruption in Hawaii. But now there has been in the news an eruption in Guatemala. Any connection between the two?
TANYA BASU: No. No, I talked to a volcanologist or volcanologist. I’m not sure how you pronounce that.
IRA FLATOW: Well, either way.
TANYA BASU: Yeah. Well, I talked to an expert.
IRA FLATOW: Tomato or tomato.
[LAUGHS]
TANYA BASU: And she was very much like, absolutely not, two different plates, nothing connected. There’s 25 volcanoes a day and you never hear about those. So not connected at all. But needless to say, extremely violent volcano that just erupted in Guatemala. Over 70 people dead, many missing.
IRA FLATOW: Yeah, it’s terrible.
TANYA BASU: It’s just really rough.
IRA FLATOW: And they have it– their volcanic eruptions are for a different reason than go on in Hawaii. Right?
TANYA BASU: Yeah. So the Hawaii one, what’s in the news, you’ll see these really spectacular images of lava and fire, basically. What’s in Guatemala is a little bit different. So it’s called pyroclastic density currents.
IRA FLATOW: If you say so.
TANYA BASU: I know. I’m just making this up right now.
[LAUGHTER]
Believe me. No, and it’s this basically this volcano version of an avalanche of rock and 1,000 degree gases. And it’s very toxic. It moves fast. It moves faster than a supersonic airplane.
IRA FLATOW: Wow!
TANYA BASU: And you see these videos of people shooting video of it coming down. And many experts are like, why are you doing this? This thing is moving at 450 miles per hour, it’s going to just–
IRA FLATOW: Get out of there.
TANYA BASU: Just leave.
[LAUGHTER]
So it’s very dangerous. And Guatemala is in its rainy season right now. So mudslides to come as well.
IRA FLATOW: Let’s talk about probably a lot of people’s favorite story of the week and that’s the peacock attacks in British Columbia.
TANYA BASU: Yeah.
IRA FLATOW: What’s going on there?
TANYA BASU: All right, so there was a farm and the farm got closed. And these peacocks were just sitting in a tree, some guy cut the tree, and the peacocks went loose. They go and see these cars that are super shiny, see their reflections, and instead of their reflections think of them as their rivals and hack at the cars.
IRA FLATOW: And so they’re denting up the cars and making dimples all over the car?
TANYA BASU: They’re denting up all those cars.
[LAUGHTER]
IRA FLATOW: And how do they stop? Why did they stop? After a while, they can’t see themselves, so they say, hey?
TANYA BASU: There are reports of them destroying completely front panel, back panel. They just keep going until they don’t see the reflection anymore. So they are very determined.
[LAUGHS]
IRA FLATOW: And they can’t do anything about the peacocks.
TANYA BASU: No, no, no. They were originally reported to be screaming at night, which is why this guy cut down the tree. But maybe it was better for them to scream.
IRA FLATOW: But he moved out of town. Right?
TANYA BASU: I mean, at this point he should.
[LAUGHTER]
IRA FLATOW: Great story. Nice to have you, Tanya.
TANYA BASU: Thank you.
IRA FLATOW: Tanya Basu is a Editor at The Daily Beast here in New York.
Copyright © 2018 Science Friday Initiative. All rights reserved. Science Friday transcripts are produced on a tight deadline by 3Play Media. Fidelity to the original aired/published audio or video file might vary, and text might be updated or amended in the future. For the authoritative record of Science Friday’s programming, please visit the original aired/published recording. For terms of use and more information, visit our policies pages at http://www.sciencefriday.com/about/policies/
As Science Friday’s director and senior producer, Charles Bergquist channels the chaos of a live production studio into something sounding like a radio program. Favorite topics include planetary sciences, chemistry, materials, and shiny things with blinking lights.